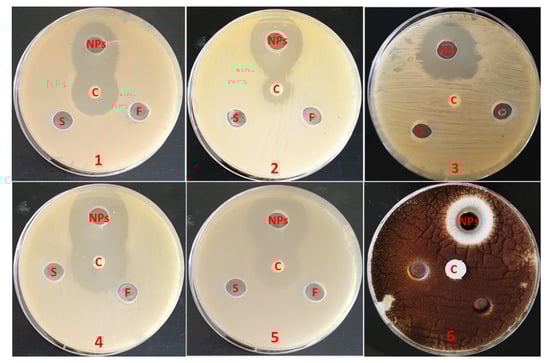

Abstract
In this study, a sustainable and eco-friendly method was used to prepare zinc oxide nanoparticles (ZnO-NPs) using a sea cucumber aqueous extract. Then, ZnO-NPs were characterized by instrumental analysis (UV-vis, HR-TEM, XRD, FT-IR, and DLS) and evaluated for their possible antibacterial, antifungal, and insecticidal activities. Additionally, the toxicity of ZnO-NPs was evaluated in vivo against Nile Tilapia (Oreochromis niloticus). The sea cucumber was collected from the Gulf of Suez (Red Sea) at Al-Ain Al-Sokhna coast in Egypt and identified as Holothuria impatiens. The prepared Hi-ZnO-NPs peaked at 350 nm in UV–Vis spectral analysis. They showed quasi-spherical shaped particles with sizes ranging from 13 nm to 47 nm and a predominate size of 26 nm as indicated by HR-TEM. The XRD pattern of Hi-ZnO-NPs revealed a crystalline phase with an average size of 17.2 nm as calculated by Debye–Scherrer equation. FTIR analysis revealed the possible role of H. impatiens biological molecules in the biosynthesis process of ZnO-NPs. Hi-ZnO-NPs showed a negative zeta potential of −19.6 mV, demonstrating moderate stability. Biosynthesized Hi-ZnO-NPs revealed broad antimicrobial activity against Gram-positive bacteria (S. aureus ATCC 25923 and E. feacalis), Gram-negative bacteria (S. typhi, K. pneumonia and E. coli), and filamentous fungi (Aspergillus niger). Hi-ZnO-NPs demonstrated larvicidal activity against the mosquito, Culex pipiens (LC50 = 2.756 ppm and LC90 = 9.294 ppm), and adulticidal action against the housefly, Musca domestica (LD50 = 4.285 ppm and LD90 = 22.847 ppm). Interestingly, Hi-ZnO-NPs did not show mortality effects against Nile tilapia fish (Oreochromis niloticus), highlighting the potential safety of Hi-ZnO-NPs to highly exposed, non-target organisms. However, histopathological and hematological investigations provided dose-dependent impacts of Hi-ZnO-NPs to Nile tilapia. Overall, data provide an eco-friendly approach for synthesizing novel Hi-ZnO-NPs with multiple biomedical properties and potentially low toxicity to Nile tilapia fish.
1. Introduction
Nanotechnology is a branch of science that deals with synthesis, characterization, modification, and application of nanosized materials in diverse fields. It has shown a very rapid growth in fabrication of novel nanostructured materials with promising therapeutic uses in various medical applications. Due to the unique physicochemical properties and enhanced performance offered by nanosized materials, nanotechnology has reached almost all fields with outstanding applications [1]. Metal oxide nanoparticles particularly zinc-oxide nanoparticles (ZnO-NPs) have trended the field due to their properties and extensive interest and usage.
Marine environments are among the richest and most complex ecosystems in terms of biological and chemical diversity [2,3]. There is no doubt that the marine environment is a very rich source of bioactive molecules [4,5]. All of the progressive improvements in the past five decades of marine environment exploration have resulted in isolation of approximately 24,662 structurally unique new bioactive compounds from marine organisms [6]. Recently, most scientists focused on investigating invertebrates and their purified compounds against human pathogens. Among marine invertebrates, the sea cucumber (Class Holothuroidea) has shown economic importance as a tonic food and its involvement in folk medicine in Asia. Out of 1400 species of sea cucumbers all over the world, at least 60 species were harvested by artisanal and trawl fishing due to their commercial interests. Holothuria impatiens (Family: Holothuriidae) is a cryptic species and possesses a wide range of bioactive ingredients. Due to their importance, their abundance is a vital issue and attempts to culture them is highly recommended [7,8]. Tropical sea cucumber mariculture has the potential to become a commercial industry and contribute towards natural population restocking [8]. Nutritionally, sea cucumbers have an impressive profile of valuable nutrients such as vitamins, minerals and amino acids. They have many unique biological activities including antimicrobial, antioxidant, anticancer, anti-inflammatory, antihyperglycemic, anticoagulant, antihyperlipidemic, antihypertensive, and radioprotective [9,10].
Antimicrobial resistance is an urgent threat to global public health and development. The spreading of multi-drug resistance among community (outside hospitals)-associated bacteria is an additional threat and critical challenge to the global health [11,12]. However, increasing antimicrobial-resistant infections indicate that novel products are urgently needed to control antimicrobial-resistant microbes and reduce the emergence and spread of new forms of resistance outside hospitals [13]. Metal nanoparticles have been introduced as effective treatment platforms to fight life-threatening infections as they have shown activity against multidrug resistant bacteria in vitro [14,15,16,17]. Mosquitoes are the most important group of insects to public health as they transmit various diseases, such as malaria, filariasis, and dengue causing millions of deaths every year [18,19]. Among mosquitoes, Culex pipiens is the most common mosquito vector through urban and sub-urban areas of Africa. C. pipiens is the main vector of lymphatic filariasis. The house fly, Musca domestica (Diptera: Muscidae) is a well-known livestock pest of public health importance. It constitutes a worldwide problem wherever poor sanitation and bad hygienic conditions exist [20,21]. Moreover, the biology and ecology of dipterous flies make them ideal organisms to carry and disseminate human and animal pathogens such as helminth parasites, protozoan cysts, viruses, and bacteria [22]. Due to the developed resistance to chemical insecticides and their harmful side effects on non-target populations, investigating an alternative source with common insecticidal properties is needed. So, a marine environment may consider a rich source of novel compounds and derivatives with potential insecticidal properties that could alternate chemical insecticides.
In the present study, we synthesized ZnO-NPs using the aqueous extract of Holothuria impatiens (sea cucumber) as an ecofriendly, novel, and cost-effective approach. Biosynthesized Hi-ZnO-NPs were fully characterized, and evaluated for their antimicrobial, larvicidal, and adulticidal activities and potential toxicity toward Nile Tilapia fish (Oreochromis niloticus as a non-target model.
2. Materials and Methods
2.1. Sampling, Preservation and Identification of Sea Cucumber
Sea cucumber was collected during the spring season of 2021 by snorkeling at a one-meter depth in the Gulf of Suez (Red Sea) at Al-Ain Al-Sokhna coast in Egypt. Gulf of Suez is the northwestern arm of the Red Sea to the west of the Sinai Peninsula and it extends south-north from its mouth at the Strait of Jubal to its head at the city of Suez (314 km) and linked to the Mediterranean Sea by the vital shipping route, Suez Canal. After collection, specimens were washed with seawater and preserved in ice box containing ice cubes and a few pinches of table salt at −20 °C until processing. Sea cucumber was identified as Holothuria impatiens on the basis of morphological characters [23,24,25,26].
2.2. Holothuria Impatiens Aqueous Extract Preparation
To prepare the aqueous extract, sea cucumber was extensively washed with tap water, chopped into small pits, homogenized (300 gm) with distilled water (250 mL) and methanol (250 mL) in a tightly closed jar, and stored in dark at −20 °C. After one week, the mixture was filtered through a Whatman 542 filter paper [27].
2.3. Biosynthesis of ZnO-NPs Using Holothuria Impatiens Extract
To obtain cell debris-free extract, the aqueous extract of H. impatiens was filtered through a cotton filter, then centrifuged at 10,000 rpm for 15 min and the supernatant was collected. The collected extract was added at a ratio of 1:1 (v/v) to 1.5% (w/v) zinc acetate solution (Zn (CH3CO2)2.2H2O, HiMedia, Mumbai, India), as a zinc precursor. The reaction mixture was adjusted to pH 7.0 and incubated for 72 h (37 °C, 120 rpm, in dark) [28]. Biosynthesized Hi-ZnO-NPs were detected by the formation of cloudy color. Hi-ZnO-NPs were harvested by centrifugation (10.000 rpm for 15 min) and extensively washed with sterile deionized water to remove any leftover biological molecules. The purified Hi-ZnO-NPs were resuspended with sterile deionized water and dried at 90 °C. Before characterization, Hi-ZnO-NPs powder was resuspended in 10 mL deionized water [29].
2.4. Characterization of Hi-ZnO-NPs
Hi-ZnO-NPs were characterized according to Barzinjy and Azeez [30]. The UV–visible absorption spectra of Hi-ZnO-NPs were measured using a Hitachi U-2800 (290–710 nm). Fourier transform infrared spectroscopy (FTIR) spectra were taken in the 400–4000 cm–1 range using an Agilent system Cary 630 FTIR model. The collected spectral data were compared to the reference chart to determine the functional groups present in the sample. High-resolution transmission electron microscopy (HR-TEM) (JEOL 2100, Tokyo, Japan) was used to examine the morphology of Hi-ZnO-NPs. X-ray diffraction (XRD) was used to study the crystalline structure of Hi-ZnO-NPs using the Shimadzu apparatus with nickel-filter and Cu-Ka target (Shimadzu Scientific Instruments, Kyoto, Japan). Zeta potential of the nanoparticles in the solution was determined by Litesizer 500 (Anton Paar, Graz, Austria) using electrophoretic light scattering.
2.5. Antimicrobial Activities of Hi-ZnO-NPs
Microbial cultures of Salmonella typhi, Klebsiella pneumonia, Escherichia coli, Staphylococcus aureus ATCC 25923, Enterococcus feacalis, and Aspergillus niger were kindly provided by the Bacteriology Laboratory, Botany and Microbiology Department, Faculty of Science, Al-Azhar University. The antimicrobial activity was determined against bacteria and fungus (A. niger) on Muller Hinton agar (MHA) and potato dextrose agar (PDA), respectively. On the surface of prepared MHA and PDA, a 24-h-old culture of bacteria and a 7-day-old culture of fungus were cultured. A sterile cork borer was used to cut 8 mm wells; 100 µL of Hi-ZnO-NPs suspension (5 mg/mL), aqueous extract of H. impatiens, and 1.5% (w/v) zinc acetate solution were applied to each well separately. Standard paper discs (6 mm) containing chloramphenicol 30 µg/disc and fluconazole 25 µg/disc were employed as controls for bacteria and fungi, respectively. The plates were left for 2 h at 4 °C followed by incubation for either 24 h at 37 °C (for bacteria) or 96 h at 28 °C (for fungi). The experiment was repeated three times, and the inhibition zones were measured and documented after incubation [31].
2.6. Insecticidal Bioassays of Hi-ZnO-NPs
Egg rafts of laboratory reared Culex pipiens mosquitoes were obtained from the colony established at Faculty of Science, Al-Azhar University, Cairo, Egypt. The hatched larvae were provided ad libitum with fish food as a diet. The house fly, Musca domestica (L.) adults used in the study were fed on sugar solution and water dissolved milk powder (10% w/v). Both tested insects were maintained at laboratory conditions of 27 ± 2 °C, 70 ± 5% relative humidity (RH), with 14–10 h photoperiod in the insectary of Medical Entomology, Faculty of Science, Al-Azhar University, Egypt [32,33]. For toxicity bioassays, preliminary experiments were conducted to estimate the appropriate range of concentrations for further application on both tested insects.
The larvicidal activity of biosynthesized Hi-ZnO-NPs against Culex pipiens was evaluated according to the World Health Organization protocol [34], with minor modifications. Briefly, twenty-five 3rd larval instar were subjected to serial concentrations of Hi-ZnO-NPs (0.5, 1, 2, 4, and 8 ppm), in five replicates with including a negative control (distilled water) and a positive control (1 ppm temephos). Larval mortality was recorded 24 h post-treatment to calculate lethal concentrations. Later, lethal concentrations (LC50 and LC90) were determined and used for further non-target experiments. The adulticidal activity of the adult house fly (Musca domestica) was evaluated using the topical application method described by Wright [35]. Briefly, ten adults from both sexes (3-days old) were anesthetized with diethyl ether for 3 min then 1 μL of Hi-ZnO-NPs (doses: 0.5, 1, 2, 4, and 8 μg/adult) was applied by Hamilton microliter syringe 701-N (Sigma-Aldrich) on the dorsal thorax alongside with a negative control (distilled water) and Cypermethrin (Dethriod 10®, 10% w/v cypermethrin, Pentacheme Co. Ltd., Thailand) as a positive control at a concentration of 1 μL/adult. Each concentration was replicated five times. Adulticidal activity was recorded 24 h post-treatment.
2.7. Toxicity of Hi-ZnO-NPs
This experiment aimed to determine the potential hazards of biosynthesized Hi-ZnO-NPs to the non-target Nile Tilapia fish (Oreochromis niloticus). Apparently healthy sex-reversed (all male) fingerlings were purchased from a commercial hatchery in Sharkia Governorate, Egypt. The fingerlings were transported using a fish transport vehicle supplied with aeration tools. Fingerlings were adapted to the experimental condition for 15 days before starting the experiment. Four concentrations 10 times higher than the obtained LC50 concentration for larval treatment (10, 20, 40, and 80 ppm) were applied against O. niloticus (average initial weight 30.21 ± 0.47 g) in glass aquaria (40 × 25 × 30 cm) alongside with the controls in 3 replicates per each treatment according to Mount [36]. Each aquarium (5 fishes/aquarium) was filled with 20 Liter water and this level was maintained throughout the experimental period. All experimental aquaria were supplied with dechlorinated tap water through a water pipeline system supplied with an air pipeline using an air blower 2 HP.
2.7.1. Water Quality Parameters
Several water parameters such as temperature, dissolved oxygen, pH and total ammonia concentration were recorded throughout the experiment period.
2.7.2. Experimental Diet
All fish groups were fed on commercial diet contains ingredients with chemical composition as shown in Table 1. Fish were fed at the rate of 3% of body weight per day and food was daily provided at three time points (8, 12 and 15 h).

Table 1.
Diet formulation and proximate analysis (g/kg).
2.7.3. Histological and Hematological Assays
Tissue samples from the gills and the liver from Hi-ZnO-NPs-treated and untreated fish were fixed by formaldehyde (10%) for 24 h. After fixation, the tissues were dehydrated (in a series of ethanol/water washes of increasing concentrations), diaphonized, and embedded in plastic paraffin. Subsequently, 5 mm thick cuts were precisely made in automatic microtome. The sections were stained with hematoxylin-eosin [37].
Blood samples were collected from the caudal vertebral vein of an anaesthetized fish at the end of the feeding experiment then divided into two groups, one containing EDTA (as anticoagulant) for hematological examination, and the other without EDTA for serum investigations. Reb blood cells (RBCs) and white blood cells (WBCs) were counted using hemocytometer and Natt-Herrik solution. Hemoglobin (Hb) concentration was determined using the cyanomet hemoglobin method Drabkin’s solution. The micro hematocrit method was used for estimation of the packed cell volume (PCV) % to measure RBCs mass. Mean corpuscular volume (MCV), mean corpuscular hemoglobin (MCH), and mean corpuscular hemoglobin concentration (MCHC) were assessed. Differential leukocytic count (DLC) was calculated according to the following formula: Absolute DLC = no. of white cells X no. of total leukocytic count/100. Serum total proteins, albumins, aspartate aminotransferase, alanine aminotransferase, triglycerides, creatinine, cholesterol, glucose, urea were determined colorimetrically at their corresponding wavelengths. Globulins content was calculated mathematically. Superoxide dismutase, catalase, lipid peroxide, lipase, and amylase, was determined colorimetrically their corresponding wavelengths. Serum lysozyme was assayed by ELISA based on the ability of lysozyme to lyses Gram positive lysozyme sensitive bacterium; Micrococcus lysodeikticus (Sigma, USA) at the wavelength 450 nm. Immunoglobulin M (IgM) was measured by ELISA using a commercial kit (Bioneovan.co., Beijing, China).
2.8. Statistical Analysis
Mean and standard error (SE) were calculated for each treatment. Larval and adult mortality data were subjected to probit analysis to calculate LC50, LC90, LD50, and LD90 at 95% confidence limits. ANOVA and Chi-square values were evaluated using SPSS (ver. 25). For pairwise comparisons, Tukey HSD post hoc test was applied. p value was considered significant at <0.05.
3. Results
3.1. Identification of Sea Cucumber
Based on morphological characteristics, as shown in Figure 1, the collected sea cucumber was identified as Holothuria (Thymiosycia) impatiens (Forsskål, 1775). H. impatiens has shown a tough, brown spotted, elongated cylindrical shape with a tough tegument, prominent papillae, and a firm but pliable body. Its skin color is variegated grey, brown, or purplish-brown, with alternating bands of pale and dark color. Its skin surface is covered with conical spiky bumps to distinguish it from other close strains such as H. hilla. H. impatiens can be found in shallow reefs, hidden below rocks, in seagrasses, and in silty environments up to 30 m in depth. It is characterized by its crown of about twenty feeding tentacles at the anterior end.

Figure 1.
Sea cucumber; Holothuria impatiens. Kingdom: Animalia, Phylum: Echinodermata, Class: Holothuroidea, Order: Holothuriida, Family: Holothuriidae, Holothuria (Thymiosycia) impatiens (Forsskål, 1775).
3.2. Characterization of Biosynthesized Hi-ZnO-NPs
Visual observation of the reaction mixture of H. impatiens extract and zinc acetate solution provided preliminary proof for the formation of Hi-ZnO-NPs. This was indicated by the appearance of a cloudy to milky-colored mixture, followed by the development of white to off-white precipitates at the bottom of the flasks. UV–Vis spectroscopy of a colloidal solution containing Hi-ZnO-NPs was screened in the range of 290–710 nm to confirm the reduction of Zn2+ to Hi-ZnO-NPs. The UV–Vis spectra of the Hi-ZnO-NPs sample revealed a prominent peak at 350 nm, which is a characteristic feature of zinc oxide nanoparticles (Figure 2A). The morphology of Hi-ZnO-NPs was examined by High-Resolution Transmission Electron Microscopy (HR-TEM) and showed quasi-spherical shaped particles with a broad size distribution (13–47 nm, the predominate size was 26 nm, and the average particle size was 26.95 ± 8.63 nm). HR-TEM images revealed that the majority of the particles exist separately, however, certain HR-TEM images show few aggregated particles (Figure 2B,C).



Figure 2.
Characterization of Hi-ZnO-NPs mediated by Holothuria impatiens aqueous extract. (A) UV-visible spectrum of Hi-ZnO-NPs. (B) HR-TEM image and size distribution chart of Hi-ZnO-NPs. (C) XRD pattern of Hi-ZnO-NPs. (D) Zeta potential of Hi-ZnO-NPs. (E) FTIR of Hi-ZnO-NPs.
X-ray diffraction (XRD) pattern indicated a crystallite phase of Hi-ZnO-NPs with an average size of 17.2 nm based on the Debye–Scherrer equation. The XRD profile also revealed strong and prominent peaks at 31.74, 34.17, 36.11, 47.52, 56.32, 62.76, and 67.79, which were categorized as planes (100), (002), (101), (102), (110) (103), and (112) (Figure 2D). These peaks corresponded well with wurtzite ZnO criteria from the Joint Committee on Power Diffraction (JCPD), file number (00-005-0664). Thus, the XRD pattern revealed that Hi-ZnO-NPs had a fine hexagonal crystalline structure which exhibited a good agreement with this reference model. Given the absence of any other distinct diffraction peaks, the formed Hi-ZnO-NPs were free of impurities and with a high phase purity. Zeta potential value of Hi-ZnO-NPs in colloidal solution has shown a negative zeta potential of −19.6 mV, indicating a moderate stability (Figure 2E). Fourier transform infrared spectroscopy (FTIR) was used to investigate the potential role of biological molecules from H. impatiens aqueous extract in the synthesis of Hi-ZnO-NPs. The findings showed substantial absorption spectra ranging from 400 to 4000 cm−1 (Figure 2F) with existence of an absorption band at 545 cm−1, a sharp peak at 1642 cm−1, a weak absorption at 2080 cm−1 and a peak at 3460 cm−1.
3.3. Antimicrobial Activities of Biosynthesized Hi-ZnO-NPs
The antimicrobial efficacy of Hi-ZnO-NPs was evaluated against Gram-positive bacteria (S. aureus ATCC 25923 and E. faecalis), Gram-negative bacteria (S. typhi, K. pneumonia, and E. coli), as well as filamentous fungi (A. niger). The data represented in (Table 2 and Figure 3) showed that Hi-ZnO-NPs have antimicrobial activities against all investigated microorganisms, with inhibition zones ranging from 22 nm to 30 mm.

Table 2.
Antimicrobial potential of biosynthesized Hi-ZnO-NPs.
Figure 3.
Antimicrobial activities of Hi-ZnO-NPs (NPs), H. impatiens aqueous extract (F), Zinc acetate solution (S), and standard antibiotics (C) against S. typhi (1); K. pneumonia (2); E. coli (3); S. aureus (4); E. faecalis (5), and A. niger, (6) using agar diffusion assay. Measurements were conducted in triplicates per each sample.
On one side, H. impatiens extract and precursor solution (zinc acetate) did not show any activity against the examined microorganisms. On the other side, Chloramphenicol, a standard antibiotic, had a considerable effect on both S. typhi, S. aureus ATCC 25923 and E. feacalis, with inhibition zones ranging from 21 nm to 27 mm. It also had an intermediate activity (inhibition zone = 14 mm) on K. peumonia, but not on E. coli. Furthermore, there was no action seen by fluconazole, which was utilized as the standard antifungal in this study, against A. niger.
3.4. Insecticidal Assay of Biosynthesized Hi-ZnO-NPs
Data obtained in (Table 3 and Table 4) exhibited a gradual increase in mortality of tested Hi-ZnO-NPs against both tested insects. For C. pipiens larvae, tested materials were extremely effective against the 3rd larval instar. The maximum toxicity level was reached when 8 ppm concentration of Hi-ZnO-NPs was applied, while the lowest toxicity was obtained when 0.5 ppm concentration was applied. The recorded LC50 value (2.756 ppm) and the LC90 value (9.294 ppm) was calculated 24 h post exposure. These results were significantly different among tested concentrations (d. f. = 4, p < 0.05 and χ2 = 23.943) except those of 0.5 ppm. Zinc acetate solution did not exhibit any larval mortality.

Table 3.
Larvicidal activity of Hi-ZnO-NPs against the 3rd larval instar of the mosquito vector, Culex pipiens.

Table 4.
Adulticidal activity of Hi-ZnO-NPs against the housefly, Musca domestica adults.
For M. domestica, topical assay revealed that tested materials greatly increased adult mortality with LD50 value of (4.285 μg/adult) and LD90 value of (22.847 μg/adult) calculated 24 h post exposure. These results were significantly different among tested concentrations (d. f. = 4, p < 0.05 and χ2 = 5.852) except those of 0.5 ppm. The high chi-square values indicate the homogeneity of tested populations. Zinc acetate did not exhibit any adulticidal activity. In general, C. pipiens larvae were much more sensitive to our biosynthesized Hi-ZnO-NPs than the M. domestica adults.
3.5. Toxicity of Biosynthesized Hi-ZnO-NPs
A preliminary experiment was conducted to determine the potential hazards of biosynthesized Hi-ZnO-NPs against the non-target fish, O. niloticus, following chronic exposure. Hi-ZnO-NPs (10, 20, 40, and 80 ppm) did not show any mortality against the non-target model O. niloticus. Water parameters did not show any significant differences due to applied concentrations with average temperature of 22.61 ± 1.04 °C, dissolved oxygen 5.64 ± 0.46 mg/L, pH 7.10 ± 0.23 and total ammonia concentration was 0.22 ± 0.02 mg/L.
3.5.1. Gill Histopathology
Histopathological study of the gills revealed ideal structural organization of the lamellae in the control group without pathological alterations. The alterations of gills of Hi-ZnO-NPs-treated Nile tilapia, Oreochromis niloticus were dose-dependent. Fish exposed to the lowest concentration of Hi-ZnO-NPs (10 ppm) showed several gill histopathological alterations, lamellar fusion, lamellar epithelium lifting, proliferation of filamentary epithelium. Hyperplasia of primary epithelial cells, necrosis, and strong lamellar epithelium lifting were observed in gills exposed to 20 ppm Hi-ZnO-NPs. Furthermore, 40 ppm Hi-ZnO-NPs resulted in some visible aberrations to the structure of the gill tissues manifested by filament epithelium proliferation, edema, aneurisms, and presence of some necrotic cells. Exposure of fish to high concentration of Hi-ZnO-NPs (80 ppm) revealed hyperplasia of primary epithelial cells, edema in the filamentary epithelium, necrotic cells, and wrinkles of primary lamellae (Table 5, Figure 4A–E).

Table 5.
Histopathological lesions on gills of Nile tilapia, O. niloticus exposed to Hi-ZnO-NPs.


Figure 4.
Photomicrographs of the gills of Nile tilapia, O. niloticus exposed to different conecntrations of Hi-ZnO-NPs. (A) Gills of unexposed Nile tilapia (control) showing secondary lamellae (red arrow), primary lamellae (black arrow) and epithelial cells (green arrow) (B) Gils of Hi-ZnO-NPs (10 ppm)-treated O. niloticus showing induced Lamellar fusion (black arrow) lamellar lifting (yellow arrow), normal central venous sinus (blue arrow), congestion of blood vessels (brown arrow), proliferation of filamentar epithelium (red arrow). (C) Gils of Hi-ZnO-NPs (20 ppm)-treated O. niloticus demonstrating Hyperplasia (black arrow), necrosis (green arrow), lamellar epithelium lifting (blue arrow), vasodilatation (yellow arrow) and congestion of blood vessels (red arrow). (D) Gils of Hi-ZnO-NPs (40 ppm)-treated O. niloticus showing proliferation (black arrow), that in some instances conduced to lamellar fusion (purple arrow), edema (yellow arrow), Aneurisms in the apical region of the lamellar vascular axis (green arrow), epithelium lifting (brown arrow) and presence of some necrotic cells (red arrow). (E) 80 ppm Hi-ZnO-NPs treatment showing gils with hyperplasia (green arrow), edema (red arrow), extreme dilation of the central venous (yellow arrow), proliferation of filamentar epithelium (black arrow) and necrotic cells in the primary secondary lamella (brown arrow). Stain H&E. Bar = 50 µm.
3.5.2. Liver Histopathology
In the control group, the liver displayed a normal architecture with no pathological abnormalities. Likewise to gills, the liver tissue changes of Hi-ZnO-NPs-treated fish were dose-dependent. The dose of 10 ppm Hi-ZnO-NPs revealed hepatopancreatic damage and cytoplasmic vacuolation, necrosis, and pyknotic nuclei. Fish exposed to 20 ppm showed hepatocellular necrosis and hepatic cord disarrangement, cytoplasmic vacuolation, and hemorrhage. The histological alterations in liver were more evident in fish group exposed to 40 ppm, where the nuclei were displaced to the cell periphery, stasis within the sinusoid’s capillaries were observed, and signs of extreme necrosis were evident. Hepatocyte hypertrophy was detected in the fish group exposed to 80 ppm and stasis within the sinusoid’s capillaries was infiltration by inflammatory cells and cytoplasmic vacuolation with extreme focal necrotic hepatocytes was observed (Table 6, Figure 5A–E).

Table 6.
Histopathological lesions recorded on the liver Nile tilapia, O. niloticus exposed ZnO-NPs.

Figure 5.
Photomicrographs of the liver of Nile tilapia, O. niloticus exposed to different concentrations of Hi-ZnO-NPs. (A) Unexposed (Control) liver showing hepatocyte (black arrow), spherical nucleus (yellow arrow), sinusoids (red arrow) and kupffer cells (green arrow). (B) Liver of Hi-ZnO-NPs (10 ppm)-treated O. niloticus showing cytoplasmic vacuolation (green arrow) necrosis (yellow arrow), pyknotic nuclei (brown arrow) and hemorrhage (red arrow). (C) 20 ppm treatment showing hepatocellular necrosis (yellow arrow), extreme cytoplasmic vacuolation (red star), and hemorrhage (black arrow). (D) 40 ppm treatment showing nuclei displaced to the cell periphery, stasis within the sinusoid’s capillaries (black arrow) necrosis (yellow star). (E) 80 ppm treatment showing hepatocyte hypertrophy (green arrow) and stasis within the sinusoid’s capillaries infiltrated by inflammatory cells (yellow arrow) and cytoplasmic vacuolation (black arrow) with sever focal necrotic hepatocytes (red star). Stain H&E. Bar = 50 μm.
3.5.3. Hematological Parameters
Hi-ZnO-NPs-treated fishes revealed decreased levels of RBCs, WBCs, Hb, PCV, lymphocytes, and monocytes in comparison to the control group, while heterophil counts were nearly similar in all groups (Table 7, Table 8, Table 9 and Table 10). Also, Hi-ZnO-NPs-treated fishes showed decreased serum total protein, albumin, globulin, triglycerides, and digestive enzymes (amylase and lipase) levels and increased glucose, cholesterol levels, AST, ALT, Urea, and creatinine levels. SOD and CAT levels were also increased by exposure of fishes to Hi-ZnO-NPs.

Table 7.
Hematological parameters of the Nile tilapia, O. niloticus exposed to different concentrations of biosynthesized Hi-ZnO-NPs.

Table 8.
Immune responses of the Nile tilapia, O. niloticus exposed to different concentrations of biosynthesized Hi-ZnO-NPs.

Table 9.
Serum biochemical measurements of the Nile tilapia, O. niloticus exposed to different concentrations of biosynthesized Hi-ZnO-NPs.

Table 10.
Serum antioxidant biomarkers of the Nile tilapia, O. niloticus exposed to different concentrations of biosynthesized Hi-ZnO-NPs.
Treatment of Nile tilapia with Hi-ZnO-NPs resulted in decreased lysozyme activity, phagocytic, phagocytic index and IgM levels. There was a decrease in the RBCs count, PCV and hemoglobin concentration, beside slight changes in MCV, MCH and MCHC in all treated groups. This normocytic normochromic anemia may be due to the decrease in the life span of RBCs.
4. Discussion
Biological substances (extracellular or intracellular) from various organisms can be used for fabrication of ZnO-NPs. Herein, aqueous Zn2+ (zinc acetate solution) was converted to zinc nanoparticles due to oxidation-reduction of Zn2+ by the biological compounds and functional groups present in the aqueous extract of sea cucumber H. impatiens. Biosynthesized Hi-ZnO-NPs were initially observed as a white haziness and then they precipitated [28]. Hi-ZnO-NPs peaked in the region of 350–390 nm of UV–Vis absorption spectroscopy. This was supported by several studies that showed the formation of ZnO-NPs with characteristic peaks in this region. For example, Yusof et al. [38] synthesized ZnO-NPs from Lactobacillus plantarum TA4 cell-free filtrate and the UV-Vis absorption spectrum analysis revealed an absorption peak at 350 nm. Zinc sulfate, when used as a precursor for the biosynthesis of ZnO-NPs from Ficus carica leaf extract, revealed an absorption band of 360 nm [39]. Additionally, a strong peak of 370 nm in the UV–Vis spectra of green-produced ZnO-NPs mediated by the algal extract was recorded by El-Belely et al. [40].
Morphologically, HR-TEM images showed that Hi-ZnO-NPs were quasi-spherical shaped particles with sizes that ranged from 13 nm to 47 nm and the majority of particles were 26 nm. Furthermore, HR-TEM images revealed that the generated Hi-ZnO-NPs were dispersed. The XRD pattern revealed a fine hexagonal crystalline structure of Hi-ZnO-NPs. Because the nanomaterials tend to self-aggregate owing to their surface charge, stability is a crucial parameter to consider while investigating materials. The stability of nanostructures is directly related to the zeta potential (surface potential) [41]. Therefore, zeta potential analysis was used to determine the surface charge of Hi-ZnO-NPs and demonstrated a mean zeta potential of −19.6 mV, indicating their moderate stability. A similar value (−20.9 mV) of zeta potential is obtained for ZnO-NPs synthesized using the leaf extract of Cinnamomum tamala [42]. Due to electrostatic repulsions between the single-charged NPs during dispersion, a high positive or negative value of zeta potential indicates higher physical stability. On the other hand, because of the attractive Van der Waals forces acting on them, particles with low zeta potential tend to coagulate or flocculate, probably leading to poor physical stability. According to Nithya and Kalyanasundharam [43], ZnO-NPs with zeta potential falling between 32.06 and 17.89 mV have a moderate level of stability. FTIR analysis showed existence of an absorption band at 545 cm−1, which is the distinctive indication of ZnO bonding (fingerprint), confirming that the produced materials were truly ZnO nanoparticles. The sharp peak at 1642 cm−1 is due to the carbonyl (C=O) stretching vibration of the amide I of proteins [15,44]. The weak absorption at 2080 cm−1 is due to C≡C stretching vibration and the 2350 cm−1 band is due to N–H stretching [45]. In addition, the peak at 3460 cm−1 is due to vibration of stretch O–H in water, alcohol, and phenols [46].
In line with the observed antibacterial properties of Hi-ZnO-NPs, earlier investigations have demonstrated the antibacterial activity of ZnO-NPs against both Gram-positive and Gram-negative bacteria, as well as bacterial endospores [47,48]. The mechanism of antibacterial activity of ZnO nanoparticles could be through multiple ways, including the formation of reactive hydrogen species which have harmful effects against bacteria. Another mechanism includes that ZnO nanoparticles can bind to bacterial cell surfaces and subsequently enter inside to interact with cytoplasmic components [49,50]. In this study, Hi-ZnO-NPs exhibited antifungal activity against A. niger. According to He et al. [51], treatment of fungi with ZnO-NPs greatly decreased conidial production and distorted the conidiophores of Penicillium expansum and Botrytis cinerea, demonstrating antifungal capabilities. However, more studies are required to evaluate the activities of Hi-ZnO-NPs against more microorganisms, bacterial biofilms, and mammalian cell lines. Also, evaluating the minimum inhibitory concentration and minimum bactericidal concentration for Hi-ZnO-NPs are required. Based on the properties of Hi-ZnO-NPs, the shape and morphology of ZnO-NPs can affect their ability to penetrate microbial cells and cause damage to their membranes. Furthermore, the surface area of Hi-ZnO-NPs plays a crucial role in determining their antibacterial and antifungal activities, where ZnO-NPs with a large surface area are more effective for adsorbing on the microbial cell surface and disrupting cell membrane stability, leading to increased antimicrobial activity. It is important to note that the surface charge of ZnO-NPs can also affect their antimicrobial activities. ZnO-NPs with a positive surface charge exhibit stronger antimicrobial activities against Gram-negative bacteria than Gram-positive bacteria compared to particles with a negative surface charge and vice versa. The high negative charges on surfaces of Gram-negative bacteria enable them to bind strongly with the positively charged ZnO-NPs, while negatively charged ZnO-NPs tend to bond more to cell surfaces of Gram-positive bacteria [52,53].
A gradual increase in mortalities of C. pipiens larvae (d. f. = 4, p < 0.05 and χ2 = 23.943) and M. domestica adults (d. f. = 4, p < 0.05 and χ2 = 5.852) was observed after treatment with Hi-ZnO-NPs and the rate of mortalities was concentration/dose-dependent. The high chi-square values indicate the homogeneity of tested populations. Zinc acetate and ZnO-NPs (alone) revealed no mortality. In general, C. pipiens larvae were more sensitive to our biosynthesized Hi-ZnO-NPs over the M. domestica adults. Concentration-dependent mortality results obtained here were also reported in several previous studies. Hasaballah et al. [32] found highly toxic effects of synthesized Spongia officinalis ZnO-NPs with LC50 of 31.82 ppm against C. pipiens larvae. Additionally, potent insecticidal activity of the soft coral, Ovabunda macrospiculata ZnO-NPs against M. domestica with LC50 of 22.595 ppm was also reported [54]. Such results suggest that biosynthesized Hi-ZnO-NPs from natural origins such as marine organisms could exert larvicidal/adulticidal activities through the small size of NPs that makes it easily penetrate the insect cuticle.
The in vivo toxicity of biosynthesized Hi-ZnO-NPs were evaluated in the non-target model, Nile tilapia fish (O. niloticus) through histopathological investigations of gills and livers and hematological analyses. Concentrations of Hi-ZnO-NPs used in this experiment were 10 times higher than the obtained LC50 concentration for larval treatment. Given their primary role in oxygen supply, any disturbance in gills would affect the fish’s physiological and metabolic activities. Untreated fishes revealed ideal structural organizations of the lamellae without any pathological alterations, while Hi-ZnO-NPs-treated fishes showed dose-dependent histopathological alterations in their gills. Comparable findings in the gills of different fish species were also observed by Cengiz and Unlu [55]. They reported changes in structure of the gill and gut tissues of mosquitofish (Gambusia affinis) upon treatment with sublethal concentrations of commercial Deltamethrin (insecticide recommended by WHO). Additionally, Tilak et al. [56] reported bulging in the tips of primary gill lamellae, club shaped secondary gill lamellae, extreme necrotic changes in the epithelial cells, atrophy and fusion of gill lamellae in the fish exposed to Fenvalerate (a synthetic pyrethroid insecticide). Liver tissue investigation of fishes exposed to Hi-ZnO-NPs revealed dose-dependent hepatopancreatic damage, cytoplasmic vacuolation, necrosis and pyknotic nuclei, and some other alterations compared to the control group. Similar results were obtained by Ikele et al. [57], they reported necrosis and pyknotic nuclei in the liver of fish exposed to Diethyl phthalate (DEP) (a synthetic phthalate ester with multiple applications, including as an insecticide). In another study, hyperplasia and focal necrosis were seen in the liver of Rohu fish (Labeo rohita) exposed to Carbofuran and Cypermethrin (both are synthetic insecticides widely used around the world) [58].
Some hematological parameters such as RBCs, Hb, PCV, WBCs, lymphocytes, monocytes, serum total protein, albumin, globulin, and triglycerides were decreased in Nile tilapia fish treated with Hi-ZnO-NPs. Digestive enzymes, ALT, AST, lysozyme activity, phagocytic, phagocytic index, and IgM levels were found to be affected by Hi-ZnO-NPs treatment in comparison to the control group. In harmony with these findings, Kaya et al. [59] found similar levels in the Nile tilapia during exposure to 1 mg/L of ZnO-NPs. Additionally, ZnO nanoparticles are reported to induce cytotoxic effects in zebrafish embryo and larval cell lines [60,61] which attributed to the increased production of reactive oxygen species (ROS) that overwhelms the intracellular stress and cell death. Overproduction of ROS exhausts the cellular antioxidants, and this effect may be implicated in ZnO-NPs poisoning in aquatic organisms including Nile tilapia fish [62]. ALT and AST are important parameters to identify the health status of fish as they play a major role in protein and amino acid metabolism, and changes of these two enzymes are indicators of cellular damage. Overall, although no mortality among the non-target model were recorded, the histopathological investigations and hematological parameters evaluation provided an in-depth analysis of the various side effects of our biosynthesized Hi-ZnO-NPs.
5. Conclusions
A sustainable and eco-friendly method was used to prepare zinc oxide nanoparticles (ZnO-NPs) using a sea cucumber (Holothuria impatiens) aqueous extract. Hi-ZnO-NPs were characterized by UV-Vis, HR-TEM, XRD, FT-IR, and DLS. Biosynthesized nanoparticles were stable, quasi-spherical, and with a predominant size at 17 nm. FTIR signature revealed the potential role of biological molecules from the H. impatiens aqueous extract in the synthesis of ZnO-NPs. Hi-ZnO-NPs showed wide antimicrobial activities against Gram-positive bacteria, Gram-negative bacteria, and filamentous fungi. They also induced potent larvicidal and adulticidal activities against C. pipiens and M. domestica, respectively. No mortality effects on the non-target model (Nile tilapia fish) after exposure to increasing doses of Hi-ZnO-NPs. Histopathological investigations and hematological parameters indicated dose-dependent impacts of Hi-ZnO-NPs to Nile tilapia fish. From a future perspective, using Hi-ZnO-NPs as a tool for controlling C. pipiens and M. domestica populations and combating microbial infections can be deeply studied for their action mechanisms and investigating the persistence and degradation of ZnO nanoparticles in the environment. Additionally, more in vivo toxicity studies of Hi-ZnO-NPs against multiple organisms are required. Furthermore, Hi-ZnO-NPs could be captured on other materials to avoid their release and spreading in the environment, thus decreasing any possible detrimental side effects on the environmental flora and organisms.
Author Contributions
Conceptualization, A.I.H. and M.A.E.; Formal analysis, A.I.H., M.A.E., F.A.-O., R.M.A. and I.E.A.-E.R.; Investigation, A.I.H., M.A.E., M.H.K., O.F.A., M.M.M., A.G.A.G., I.E.A.-E.R. and M.F.A.-K.; Methodology, A.I.H., M.A.E., H.A.E.-N., O.F.A., M.H.K., M.M.M., S.A.M., M.F.A.-K. and A.G.A.G.; Supervision, A.I.H. and M.A.E.; Visualization, O.F.A., S.A.M., I.E.A.-E.R., F.A.-O., R.M.A. and H.A.E.-N.; Writing—original draft preparation, A.I.H., M.A.E., M.H.K., H.A.E.-N., O.F.A., I.E.A.-E.R., F.A.-O., R.M.A., M.M.M., A.G.A.G. and M.F.A.-K.; Writing—review and editing, A.I.H., F.A.-O., R.M.A., M.H.K. and M.A.E. All authors have read and agreed to the published version of the manuscript.
Funding
The study was funded by the Researchers Supporting Project number (RSP2023R114), King Saud University, Riyadh, Saudi Arabia.
Institutional Review Board Statement
The animal study protocol was approved by the Institutional Aquatic Animal Care and Use Committee at Kafrelsheikh University (IAACUC-KSU-130-2022).
Informed Consent Statement
Not applicable.
Data Availability Statement
We will provide all data generated in this study upon request.
Acknowledgments
The authors extend their appreciation to the Researchers Supporting Project number (RSP2023R114), King Saud University, Riyadh, Saudi Arabia, and to the Faculty of Science, Al-Azhar University for supporting this work.
Conflicts of Interest
The authors declare no conflict of interest.
References
- Chausali, N.; Saxena, J.; Prasad, R. Recent trends in nanotechnology applications of bio-based packaging. J. Agri. Food Res. 2022, 7, 100257. [Google Scholar] [CrossRef]
- Mona, M.H.; El-Naggar, H.A.; El-Gayar, E.E.; Masood, M.F.; Mohamed, E.N.E. Effect of human activities on biodiversity in Nabq Protected Area, South Sinai, Egypt. Egypt. J. Aquat. Res. 2019, 45, 33–43. [Google Scholar] [CrossRef]
- Farrag, M.M.S.; El-Naggar, H.A.; Abou-Mahmoud, M.M.A.; Alabssawy, A.N.; Ahmed, H.O.; Abo-Taleb, H.A.; Kostas, K. Marine biodiversity patterns off Alexandria area, southeastern Mediterranean Sea, Egypt. Environ. Monit. Assess. 2019, 191, 367. [Google Scholar] [CrossRef] [PubMed]
- El-Naggar, H.A.; Salem, E.-S.S.; El-Kafrawy, S.B.; Bashar, M.A.E.; Shaban, W.M.; El-Gayar, E.E.; Ahmed, H.O.; Ashour, M.; Abou-Mahmoud, M.E. An integrated field data and remote sensing approach for impact assessment of human activities on epifauna macrobenthos biodiversity along the western coast of Aqaba Gulf. Ecohydrology 2021, 15, e2400. [Google Scholar] [CrossRef]
- EL-Naggar, H.A.; Bashar, M.A.E.; Rady, I.; El-Wetidy, M.S.; Suleiman, W.B.; Al-Otibi, F.O.; Al-Rashed, S.A.; Abd El-Maoula, L.M.; Salem, E.S.; Attia, E.M.H.; et al. Two Red Sea Sponge Extracts (Negombata magnifica and Callyspongia siphonella) Induced Anticancer and Antimicrobial Activity. Appl. Sci. 2022, 12, 1400. [Google Scholar] [CrossRef]
- Metwally, A.S.; El-Naggar, H.A.; El-Damhougy, K.A.; Bashar, M.A.E.; Ashour, M.; Abo-Taleb, H.A.H. GC-MS analysis of bioactive components in six different crude extracts from the Soft Coral (Sinularia maxim) collected from Ras Mohamed, Aqaba Gulf, Red Sea, Egypt. Egypt. J. Aquat. Biol. Fish. 2020, 24, 425–434. [Google Scholar] [CrossRef]
- Sun, H.; Liang, M.; Yan, J.; Chen, B. Nutrient requirements and growth of the sea cucumber, Apostichopus japonicus. In Advances in Sea Cucumber Aquaculture and Management; Lovatelli, A., Conand, C., Purcell, S., Uthicke, S., Hamel, J.-R., Mercier, A., Eds.; FAO: Rome, Italy, 2004; pp. 327–331. [Google Scholar]
- Purcell, S.W.; Conand, C.; Samyn, Y. Commercially Important Sea Cucumber of the World; FAO Species Catalogue for Fishery Purposes No. 6. Rome; FAO: Rome, Italy, 2012; 150p. [Google Scholar]
- Hasaballah, A.I.; El-Naggar, H.A. Antimicrobial activities of some marine sponges, and its biological, repellent effects against Culex pipiens (Diptera: Culicidae). Ann. Res. Rev. Biol. 2017, 12, 1–14. [Google Scholar] [CrossRef]
- Cui, H.; Bashar, M.A.E.; Rady, I.; El-Naggar, H.A.; Abd El-Maoula, L.M.; Mehany, A.B.M. Antiproliferative activity, proapoptotic effect, and cell cycle arrest in human cancer cells of some marine natural product extract. Oxid. Med. Cell. Long. 2020, 2020, 7948705. [Google Scholar] [CrossRef]
- Abo-State, M.A.; Mahdy, H.M.; Ezzat, S.M.; Abd El Shakour, E.H.; El-Bahnasawy, M.A. Antimicrobial resistance profiles of Enterobacteriaceae isolated from Rosetta Branch of river Nile, Egypt. World Appl. Sci. J. 2012, 19, 1234–1243. [Google Scholar]
- Ezzat, S.M.; Abo-State, M.A.; Mahdy, H.M.; Abd EL-Shakour, E.H.; El-Bahnasawy, M.A. The effect of ionizing radiation on multi-drug resistant Pseudomonas aeruginosa isolated from aquatic environments in Egypt. Br. Microbiol. Res. J. 2014, 4, 856–868. [Google Scholar] [CrossRef]
- Murray, C.J.; Ikuta, K.S.; Sharara, F.; Swetschinski, L.; Aguilar, G.R.; Gray, A.; Han, C.; Bisignano, C.; Rao, P.; Wool, E.; et al. Global burden of bacterial antimicrobial resistance in 2019: A systematic analysis. Lancet 2022, 399, 629–655. [Google Scholar] [CrossRef] [PubMed]
- Ali, K.; Dwivedi, S.; Azam, A.; Saquib, Q.; Al-Said, M.S.; Alkhedhairy, A.A.; Musarrat, J. Aloe vera extract functionalized zinc oxide nanoparticles as nano antibiotics against multi-drug resistant clinical bacterial isolates. J. Coll. Inter. Sci. 2016, 472, 145–156. [Google Scholar] [CrossRef]
- Shehabeldine, A.M.; Elbahnasawy, M.A.; Hasaballah, A.I. Green Phytosynthesis of Silver Nanoparticles Using Echinochloa stagnina Extract with Reference to Their Antibacterial, Cytotoxic, and Larvicidal Activities. Bionanoscience 2021, 11, 526–538. [Google Scholar] [CrossRef]
- Pillai, A.M.; Sivasankarapillai, V.S.; Rahdar, A.; Joseph, J.; Sadeghfar, F.; Rajesh, K.; Kyzas, G.Z. Green synthesis and characterization of zinc oxide nanoparticles with antibacterial and antifungal activity. J. Mol. Struct. 2020, 1211, 128107. [Google Scholar] [CrossRef]
- Dappula, S.S.; Kandrakonda, Y.R.; Shaik, J.B.; Mothukuru, S.L.; Lebaka, V.R.; Mannarapu, M.; Amooru, G.D. Biosynthesis of zinc oxide nanoparticles using aqueous extract of Andrographis alata: Characterization, optimization and assessment of their antibacterial, antioxidant, antidiabetic and anti-Alzheimer’s properties. J. Mol. Struct. 2023, 1273, 134264. [Google Scholar] [CrossRef]
- Benelli, G. Research in mosquito control: Current challenges for a brighter future. Parasitol. Res. 2015, 114, 2801–2805. [Google Scholar] [CrossRef]
- Hasaballah, A.I. Impact of gamma irradiation on the development and reproduction of Culex pipiens (Diptera; Culicidae). Int. J. Rad. Biol. 2018, 94, 844–849. [Google Scholar] [CrossRef]
- Hasaballah, A.I. Impact of paternal transmission of gamma radiation on reproduction, oogenesis and spermatogenesis of the housefly, Musca domestica L. (Diptera: Muscidae). Int. J. Rad. Biol. 2021, 97, 376–385. [Google Scholar] [CrossRef]
- Chintalchere, J.M.; Dar, M.A.; Pandit, R.S. Biocontrol efficacy of bay essential oil against housefly, Musca domestica (Diptera: Muscidae). J. Basic Appl. Zool. 2020, 81, 6. [Google Scholar] [CrossRef]
- Fotedar, R.; Banerjee, U.; Singh, S.; Shriniwas, A.; Verma, A.K. The house fly Musca domestica as a carrier of pathogenic microorganisms in a Hospital Environment. J. Hosp. Infect. 1992, 20, 209–215. [Google Scholar] [CrossRef]
- Campbell, A.C. Echinoderms of the Red Sea; Edwards, A.J., Head, S.M., Eds.; Elsevier: Amsterdam, The Netherlands, 1987; pp. 215–232. [Google Scholar]
- Cherbonnier, G. Echinodermes: Holothuries; IRD Editions: Paris, France, 1988; 292p. [Google Scholar]
- Erwin, D.G.; Picton, B.E. Guide to Inshore Marine Life; IMMEL Publishing: London, UK, 1990; p. 219. [Google Scholar]
- Lieske, E.; Myers, R.F. Coral Reef Guide Red Sea: The Definitive Guide to over 1200 Species of Underwater Life; Harper Collins Publishers: New York, NY, USA, 2004; 211p. [Google Scholar]
- Ballantine, D.L.; Gerwick, W.H.; Velez, S.M.; Alexander, E.; Guevara, P. Antibiotic activity of lipid-soluble extracts from Caribbean marine algae. Hydrobiologia 1987, 151, 463–469. [Google Scholar] [CrossRef]
- Kalaba, M.H.; Moghannem, S.A.; El-Hawary, A.S.; Radwan, A.A.; Sharaf, M.H.; Shaban, A.S. Green synthesized ZnO nanoparticles mediated by Streptomyces plicatus: Characterizations, antimicrobial and nematicidal activities and cytogenetic effects. Plants 2021, 10, 1760. [Google Scholar] [CrossRef] [PubMed]
- Singh, M.; Kumar, M.; Kalaivani, R.; Manikandan, S.; Kumaraguru, A.K. Metallic silver nanoparticle: A therapeutic agent in combination with antifungal drug against human fungal pathogen. Bioprocess Biosys. Eng. 2013, 36, 407–415. [Google Scholar] [CrossRef] [PubMed]
- Barzinjy, A.A.; Azeez, H.H. Green synthesis and characterization of zinc oxide nanoparticles using Eucalyptus globulus Labill. leaf extract and zinc nitrate hexahydrate salt. SN Appl. Sci. 2020, 2, 1–14. [Google Scholar] [CrossRef]
- Sharaf, M.H.; Abdelaziz, A.M.; Kalaba, M.H.; Radwan, A.A.; Hashem, A.H. Antimicrobial, Antioxidant, Cytotoxic Activities and Phytochemical Analysis of Fungal Endophytes Isolated from Ocimum basilicum. Appl. Biochem. Biotechnol. 2021, 194, 1271–1289. [Google Scholar] [CrossRef] [PubMed]
- Hasaballah, A.I.; El Naggar, H.A.; Abdelbary, S.; Bashar, M.A.E.; Selim, T.A. Eco friendly Synthesis of Zinc Oxide Nanoparticles by Marine Sponge, Spongia offcinalis: Antimicrobial and Insecticidal Activities against the Mosquito Vectors, Culex pipiens and Anopheles pharoensis. BioNanoScience 2021, 12, 89–104. [Google Scholar] [CrossRef]
- Hasaballah, A.I.; Selim, T.A.; Tanani, M.A.; Nasr, E.E. Lethality and Vitality Efficiency of Different Extracts of Salix safsaf Leaves against the House Fly, Musca domestica L. (Diptera: Muscidae). Afr. Èntomol. 2021, 29, 479–490. [Google Scholar] [CrossRef]
- World Health Organization. Guidelines for Laboratory and Field Testing of Mosquito Larvicides; World Health Organization: Geneva, Switzerland, 2005; pp. 1–39. [Google Scholar]
- Wright, J.W. The WHO Programme for the Evaluation and Testing of New Insecticides. Bull. World Heal. Organ. 1971, 44, 11–12. [Google Scholar]
- Mount, D.I. Methods for Aquatic Toxicity Identification Evaluations: Phase I: Toxicity Characterization Procedures; US Environmental Protection Agency: Washington, DC, USA; Environmental Research Laboratory: Narragansett, DC, USA; National Effluent Toxicity Assessment Center United States: Duluth, MN, USA, 1988; Volume 88.
- Al-Motabagani, M.A. Histological and histochemical studies on the effects of methotrexate on the liver of adult male albino rat. Int. J. Morphol. 2006, 24, 417–422. [Google Scholar] [CrossRef]
- Yusof, H.; Rahman, A.; Mohamad, R.; Zaidan, U.H.; Samsudin, A.A. Biosynthesis of zinc oxide nanoparticles by cell-biomass and supernatant of Lactobacillus plantarum TA4 and its antibacterial and biocompatibility properties. Sci. Rep. 2020, 10, 1–13. [Google Scholar]
- Ehsan, S.; Sajjad, M. Bioinspired synthesis of zinc oxide nanoparticle and its combined efficacy with different antibiotics against multidrug resistant bacteria. J. Biomater. Nanobiotechnol. 2017, 8, 159–175. [Google Scholar] [CrossRef]
- El-Belely, E.F.; Farag, M.; Said, H.A.; Amin, A.S.; Azab, E.; Gobouri, A.A.; Fouda, A. Green synthesis of zinc oxide nanoparticles (ZnO NPs) using Arthrospira platensis (Class: Cyanophyceae) and evaluation of their biomedical activities. Nanomaterials 2021, 11, 95. [Google Scholar] [CrossRef]
- Chaudhuri, S.K.; Malodia, L. Biosynthesis of zinc oxide nanoparticles using leaf extract of Calotropis gigantea: Characterization and its evaluation on tree seedling growth in nursery stage. Appl. Nanosci. 2017, 7, 501–512. [Google Scholar] [CrossRef]
- Agarwal, H.; Nakara, A.; Menon, S.; Shanmugam, V. Eco-friendly synthesis of zinc oxide nanoparticles using Cinnamomum Tamala leaf extract and its promising effect towards the antibacterial activity. J. Drug. Del. Sci. Technol. 2019, 53, 101212. [Google Scholar] [CrossRef]
- Nithya, K.; Kalyanasundharam, S. Effect of chemically synthesis compared to biosynthesized ZnO nanoparticles using aqueous extract of C. halicacabum and their antibacterial activity. OpenNano 2019, 4, 100024. [Google Scholar] [CrossRef]
- Elbahnasawy, M.A.; Shehabeldine, A.M.; Khattab, A.M.; Amin, B.H.; Hashem, A.H. Green biosynthesis of silver nanoparticles using novel endophytic Rothia endophytica: Characterization and anticandidal activity. J. Drug Deliv. Sci. Technol. 2021, 62, 102401. [Google Scholar] [CrossRef]
- Mohammadian, M.; Es’haghi, Z.; Hooshmand, S. Green and chemical synthesis of zinc oxide nanoparticles and size evaluation by UV–vis spectroscopy. J. Nanomed. Res. 2018, 7, 00175. [Google Scholar]
- Jayarambabu, N.; Kumari, B.S.; Rao, K.V.; Prabhu, Y.T. Germination and growth characteristics of mungbean seeds (Vigna radiata L.) affected by synthesized zinc oxide nanoparticles. Int. J. Curr. Eng. Technol. 2014, 4, 2347–5161. [Google Scholar]
- Raghunath, A.; Perumal, E. Metal oxide nanoparticles as antimicrobial agents: A promise for the future. Int. J. Antimicrob. Agents. 2017, 49, 137–152. [Google Scholar] [CrossRef]
- Wagner, G.; Korenkov, V.; Judy, J.D.; Bertsch, P.M. Nanoparticles composed of Zn and ZnO inhibit Peronospora tabacina spore germination in vitro and P. tabacina infectivity on tobacco leaves. Nanomaterials 2016, 6, 50. [Google Scholar] [CrossRef]
- Sirelkhatim, A.; Mahmud, S.; Seeni, A.; Kaus, N.H.M.; Ann, L.C.; Bakhori, S.K.M.; Mohamad, D. Review on zinc oxide nanoparticles: Antibacterial activity and toxicity mechanism. Nano-Micro. Lett. 2015, 7, 219–242. [Google Scholar] [CrossRef] [PubMed]
- Tiwari, V.; Mishra, N.; Gadani, K.; Solanki, P.S.; Shah, N.A.; Tiwari, M. Mechanism of anti-bacterial activity of zinc oxide nanoparticle against carbapenem-resistant Acinetobacter baumannii. Front. Microbiol. 2018, 9, 1218. [Google Scholar] [CrossRef] [PubMed]
- He, L.; Liu, Y.; Mustapha, A.; Lin, M. Antifungal activity of zinc oxide nanoparticles against Botrytis cinerea and Penicillium expansum. Microbiol. Res. 2011, 166, 207–215. [Google Scholar] [CrossRef]
- da Silva, B.L.; Abuçafy, M.P.; Manaia, E.B.; Junior, J.A.O.; Chiari-Andréo, B.G.; Pietro, R.C.R.; Chiavacci, L.A. Relationship Between Structure And Antimicrobial Activity Of Zinc Oxide Nanoparticles: An Overview. Int. J. Nanomed. 2019, 14, 9395–9410. [Google Scholar] [CrossRef]
- Babayevska, N.; Przysiecka, Ł.; Iatsunskyi, I.; Nowaczyk, G.; Jarek, M.; Janiszewska, E.; Jurga, S. ZnO size and shape effect on antibacterial activity and cytotoxicity profile. Sci. Rep. 2022, 12, 8148. [Google Scholar] [CrossRef]
- Hasaballah, A.I.; Gobara, I.M.; El-Naggar, H.A. Larvicidal activity and ultrastructural abnormalities in the ovaries of the housefly “Musca domestica” induced by the soft coral “Ovabunda macrospiculata” synthesized ZnO nanoparticles. Egypt. J. Aquat. Biol. Fish. 2021, 25, 721–738. [Google Scholar] [CrossRef]
- Cengiz, E.I.; Unlu, E. Sublethal effects of commercial deltamethrin on the structure of the gill, liver and gut tissues of mosquitofish, Gambusia affinis: A microscopic study. Environ. Toxicol. Pharmacol. 2006, 21, 246–253. [Google Scholar] [CrossRef] [PubMed]
- Tilak, K.S.; Veeraiah, K.; Yacobu, K. Studies o histopathological changes in the gill, liver and kidney of Ctenopharyngodon idellus (Valenciennes) exposed to technical fenvalerate and EC 20%. Pollut. Res. 2001, 20, 387–393. [Google Scholar]
- Ikele, C.B.; Mgbenka, B.O.; Oluah, N.S. Histopathological effects of diethyl phthalate on Clarias gariepinus juveniles. Anim. Re. Inter. 2011, 8, 1431–1438. [Google Scholar]
- Sarkar, B.; Chatterjee, A.; Adhikari, S.; Ayyappan, S. Carbofuran- and cypermethrin-induced histopathological alterations in the liver of Labeo rohita (Hamilton) and its recovery. J. Appl. Ichthyol. 2005, 21, 131–135. [Google Scholar] [CrossRef]
- Kaya, H.; Duysak, M.; Akbulut, M.; Yılmaz, S.; Gürkan, M.; Arslan, Z.; Ateş, M. Effects of subchronic exposure to zinc nanoparticles on tissue accumulation, serum biochemistry, and histopathological changes in tilapia (Oreochromis niloticus). Environ. Toxicol. 2017, 32, 1213–1225. [Google Scholar] [CrossRef] [PubMed]
- Zhu, X.; Zhu, L.; Duan, Z.; Qi, R.; Li, Y.; Lang, Y. Comparative toxicity of several metal oxide nanoparticle aqueous suspensions to zebra fish (Danio rerio) early developmental stage. J. Environ. Sci. Health A 2008, 43, 278–284. [Google Scholar] [CrossRef] [PubMed]
- Zhu, X.; Wang, J.; Zhang, X.; Chang, Y.; Chen, Y. The impact of ZnO nanoparticle aggregates on the embryonic development of zebrafish (Danio rerio). Nanotechnology 2009, 20, 195103. [Google Scholar] [CrossRef] [PubMed]
- Hao, L.; Chen, L. Oxidative stress responses in different organs of carp (Cyprinus carpio) with exposure to ZnO nanoparticles. Ecotoxicol. Environ. Saf. 2012, 80, 103–110. [Google Scholar] [CrossRef]
Disclaimer/Publisher’s Note: The statements, opinions and data contained in all publications are solely those of the individual author(s) and contributor(s) and not of MDPI and/or the editor(s). MDPI and/or the editor(s) disclaim responsibility for any injury to people or property resulting from any ideas, methods, instructions or products referred to in the content. |
© 2023 by the authors. Licensee MDPI, Basel, Switzerland. This article is an open access article distributed under the terms and conditions of the Creative Commons Attribution (CC BY) license (https://creativecommons.org/licenses/by/4.0/).